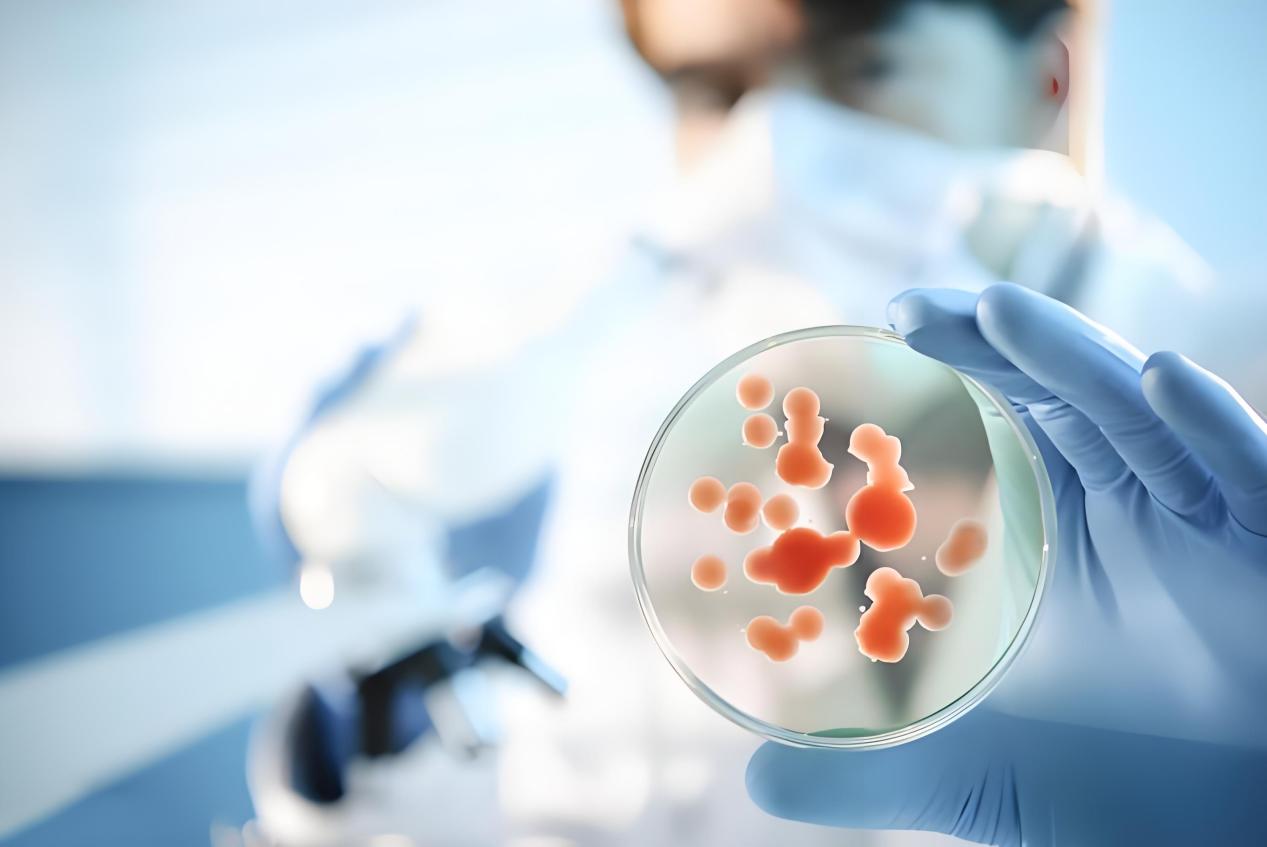

造血干细胞(Hematopoietic stem cells, HSC)是血液系统中一种成体干细胞。所有的血细胞都是造血干细胞分化而来,它是人体的“种子细胞”。


AC-1001060 CryoMax-血细胞冻存液
产品简介
CryoMax-血细胞冻存液是埃泽思生物(AppliedCell®)研发生产的一款用于冻存从脐血,外周血,骨髓中分离出来的细胞和细胞成分的产品。该产品的组成成分均使用注射级原料,同时溶剂使用注射用水配制而成。

特点优势:
* 55%(w/v) DMSO溶液
* 5%(w/v)葡聚糖 40
* 注射级原料
* 无菌过滤
* 低肉毒素
* 无支原体

AC-1001061 CryoMax-DMSO(二甲基亚砜)USP级
产品简介
CryoMax-DMSO(二甲基亚砜)USP级是埃泽思生物研发生产的一款含硫有机化合物,常温下为无色无臭的透明液体,具有高极性、高沸点、热稳定性好、非质子、与水混溶的特性。适用于细胞、组织和器官的冷冻保存,保护细胞免受冰晶引起的机械性损伤。

特点优势
* USP级,符合美国药典标准
* 产品纯度高,杂质含量低
* 无内毒素,无支原体污染

AC-1001062 CryoMAX-红细胞沉降液(6%羟乙基淀粉)
产品简介
CryoMax-红细胞沉降液(6%羟乙基淀粉)是埃泽思生物研发生产的一款红细胞聚集试剂,主要组成成分是羟乙基淀粉及氯化钠注射液,适用于从人抗凝血液中沉淀红细胞,从而分离有核细胞,无菌条件下所分离的细胞仅用于免疫学检测。
特点优势
* 原料可追溯,安全性高
* 快速沉降,维持细胞活性


AC-1001065 红细胞裂解液
产品简介
红细胞裂解液是埃泽思生物研发生产的一款利用细胞内外存在盐离子浓度差而导致细胞膜胀破的原理来裂解无核红细胞的产品。该产品适用于经酶消化分散的组织细胞的分离纯化,淋巴细胞的分离纯化以及组织细胞蛋白与核酸提取等实验中红细胞的去除。经过优化配方,该产品在裂解红细胞的同时几乎不损伤淋巴细胞或其他有细胞核的细胞。
特点优势
* 裂解效果温和
* 维持细胞活性
* 操作简便,适用于多种实验应用

AC-1001066 甲基纤维素培养基
产品简介
甲基纤维素培养基是埃泽思生物研发生产的一款用于检测从人的骨髓、外周血、脐血和白细胞单采术样本中获取的克隆原造血祖细胞的培养基。该产品支持红系祖细胞、粒细胞-巨噬细胞祖细胞以及多潜能粒细胞、红细胞、巨噬细胞和巨核细胞祖细胞的最佳生长。
特点优势
1、支持多种细胞类型:甲基纤维素培养基适用于多种细胞类型的培养,特别是造血细胞。它能够支持红细胞、粒细胞、巨噬细胞等多种细胞类型的集落形成,适用于不同研究目的和细胞类型的需求。
2、优化配方:不同的甲基纤维素培养基配方针对不同的细胞类型和研究目的进行了优化,提供了多种选择,以满足不同实验的需求。这种灵活性使得科研人员可以根据实验目的选择最适合的培养基配方。

AC-1001067 造血干细胞培养基
产品简介
造血干细胞培养基是埃泽思生物研发生产的一款无血清的培养基,专门用于支持培养中的人造血干细胞(例如 CD34+)的生长。可用于研究骨髓、外周血或新生儿脐带血中的造血细胞。由基础液体培养基和在使用时添加的冷冻添加剂组成。产品不含细胞因子和造血生长因子,可以自由使用研究所需的任何因子或因子组合,

特点优势
* 不含细胞因子和造血生长因子
* 支持细胞增殖和分化
* 无血清
造血干细胞的历史1957年,托马斯在New England Journal of Medicine上发表了关于人造血干细胞移植的第一篇论文,从而开启了造血干细胞移植的先河。
1964年1月27日,“中国骨髓移植奠基人”陆道培院士在北京大学人民医院成功进行了亚洲第1例、世界第4例异体同基因骨髓造血干细胞移植,宣告了我国造血干细胞移植事业的诞生。
1981年,在北京大学人民医院血液病科的基础上,北京大学血液病研究所成立,并成功进行了我国首例异基因骨髓造血干细胞移植。
1988年,法国医生Gluckman完成了世界第1例脐带血移植。
1990年,爱德华•唐纳尔•托马斯和“肾脏移植之父”默里被共同授予诺贝尔生理学或医学奖,以表彰他们“在用于治疗人类疾病的器官和细胞移植方法的发现”。
1996年,一名26岁的上海年轻人与一位11岁的杭州小患者,在我国第一家红十字医院——原上海医科大学附属华山医院施行了我国第一例非血缘外周血造血干细胞移植术。
造血干细胞治疗的特性造血干细胞是研究历史最长且最为深入的一类成体干细胞。一般来说,造血干细胞发挥作用主要基于其以下4大特性。

自我更新:
造血干细胞能够通过细胞分裂来维持自身的数量,保证血液系统的持续运作。
多能性:造血干细胞具有多能性,即它们可以分化成多种类型的细胞,但通常只限于血液和免疫系统的细胞。
多向分化
造血干细胞可以分化成多种血细胞,包括红细胞、白细胞(如淋巴细胞、粒细胞等)和血小板。
归巢效应
造血干细胞具有归巢能力,即它们能够迁移到骨髓中并在那里定居和增殖。
造血干细胞的临床应用造血干细胞的移植
公开数据显示,截至2024年3月,中华骨髓库提供造血干细胞移植17,232例,其中国(境)外376例。我国卫健委批准执业的7大脐带血造血干细胞库移植超50,000例,其中,北京脐血库超2,000例,天津脐血库超3,600例,上海脐血库7,024例,浙江脐血库1,181例, 山东脐血库17,902例,广东脐血库4,796例,四川脐血库1,3600例。
造血干细胞治疗血液系统疾病
造血干细胞治疗血液系统疾病是一种通过替换患者受损或异常的造血干细胞来治疗疾病的方法。这种方法可以用于治疗多种血液系统疾病,包括白血病、淋巴瘤、多发性骨髓瘤等。据公开资料显示,截止2024年3月,国家备案的158项干细胞临床研究中,有2项涉及造血干细胞。
造血干细胞研究的未来展望
1、基因编辑技术:CRISPR等基因编辑技术在造血干细胞治疗中的应用,有望提高治疗效果并减少副作用。
2、免疫耐受机制:探索免疫细胞治疗的耐受机制,以减少移植物抗宿主病(GVHD)的风险。
3、体外扩增技术:改进的体外扩增技术为造血干细胞治疗提供了更多可能,包括治疗难以治愈的疾病如白血病和淋巴瘤。
4、多能干细胞研究:利用人类多能干细胞体外造血发生体系,研究人类造血过程中的分子调控机制,以提高体外造血分化效率及品质。
5、细胞治疗与基因治疗:结合细胞治疗和基因治疗的方法,为造血干细胞治疗开辟新的治疗途径。
6、再生医学应用:利用造血干细胞在再生医学中的应用,如器官修复和疾病模型。